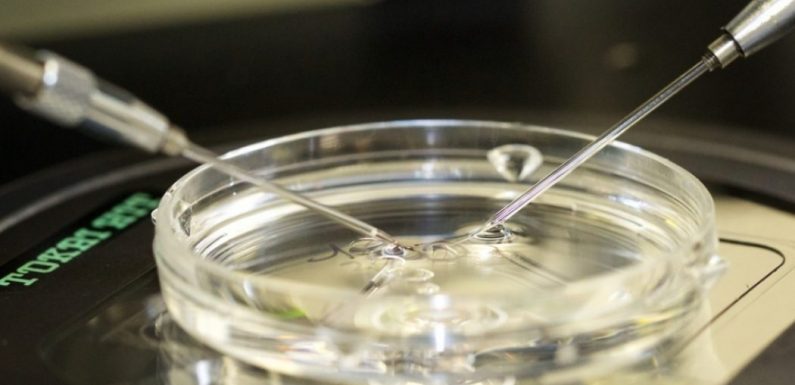
La loi de bioéthique n’ouvre pas la boîte de Pandore : celle-ci est déjà ouverte depuis 1975

Dans L’Homme Nouveau , Adélaïde Pouchol indique les 5 mesures phares de la loi de bioéthique : L’ ouverture de la procréation médicalement assistée aux femmes en couple homosexuel ou aux femmes seules, remboursée par la Sécurité sociale . Cette disposition supprime donc le critère de l’infertilité qui prévalait […]
Cliquez ici pour lire la suite La loi de bioéthique n’ouvre pas la boîte de Pandore : celle-ci est déjà ouverte depuis 1975









